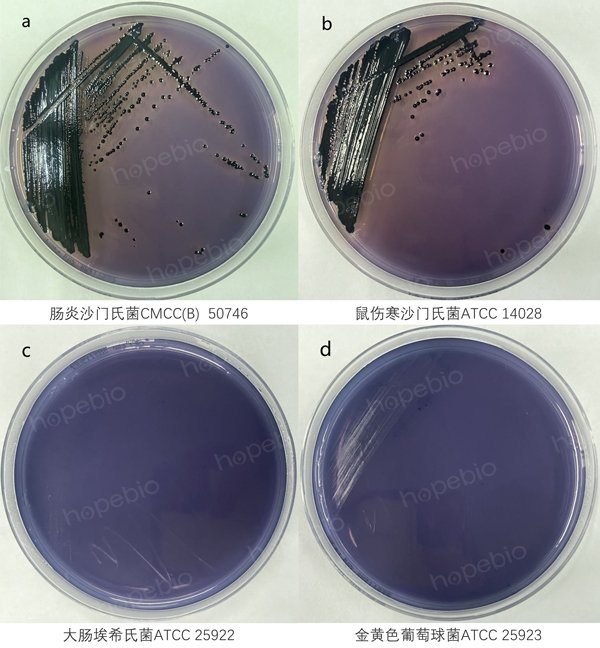

MLCB寒天培地/用于沙门氏菌分离培养
-
LB肉汤/用于细菌增菌培养
HB0128 | 见证书
-
BPL琼脂/用于沙门氏菌的分离培养
HB4204 | 见证书
-
MLCB寒天培地(颗粒)/用于沙门氏菌分离培养
HBKP8760 | 见证书
-
YM培养基
BNCC370527 | 见详情
-
沙氏琼脂培养基
BNCC370536 | 见详情
-
HLEC专用培养基
BNCC376141 | 见详情
-
鸭沙门氏菌
BNCC186373 | 见详情
-
BPL琼脂/用于沙门氏菌的分离培养
HB4204 | 见证书
-
MLCB寒天培地(颗粒)/用于沙门氏菌分离培养
HBKP8760 | 见证书
-
M2培养基
R32331-100ml | 见说明书
-
肠沙门氏菌
BNCC108207 | 见详情
-
沙门氏菌
BNCC358231 | 见详情
-
MH液体试管
BNCC391763 | 见详情
-
中国蓝培养基即用型平板
BNCC391618 | 见详情
-
肉汤培养基G(麦康凯肉汤)
BNCC391158 | 见详情
-
EG肉汤培养基
BNCC390941 | 见详情
-
蛋白瘤胃球菌培养基基础(含纤维二糖)
BNCC389132 | 见详情



用途 : 用于沙门氏菌分离培养。
用法
称取本品 49.0g,加热煮沸溶解于 1000ml 蒸馏水中,冷至 50-55℃时,倾入无菌平皿,备用。
MLCB寒天培地培养基微生物质控结果
MLCB寒天培地微生物灵敏度试验:按标签用法制备培养基,接种以下质控菌株,放置36±1℃需氧培养18-24小时。
MLCB寒天培地培养基的试验 原理、试验方法及结果
以上信息仅供参考,请以实物批次为准!
本公司销售的所有产品仅供实验科研使用,不用于人体及临床诊断。
该标准适用于微生物检测中培养基的质量控制及性能验证,涵盖食品、药品、环境监测等领域[6]。
采用选择性培养法,结合特定生化反应(如酶底物反应)进行目标菌的分离与鉴定,确保培养基的选择性和特异性[6]。
检出限通常为1 CFU/g,定量限根据样品类型和预处理方法动态调整,需通过标准菌株验证[6]。
需使用标准菌株(如阳性对照菌和阴性对照菌)进行培养基性能验证,菌株应满足活性、纯度及溯源要求[6]。
1. 培养基配制:严格按比例称量并灭菌;
2. 接种与培养:控制温度、时间及气体条件;
3. 结果判读:依据菌落形态和生化反应特征[6]。
1. 不同批次培养基需进行性能等效性验证;
2. 实验环境应符合生物安全等级要求;
3. 标准更新时需同步修订检测流程[6]。
以上信息仅供参考,请以相应标准的原文为准!